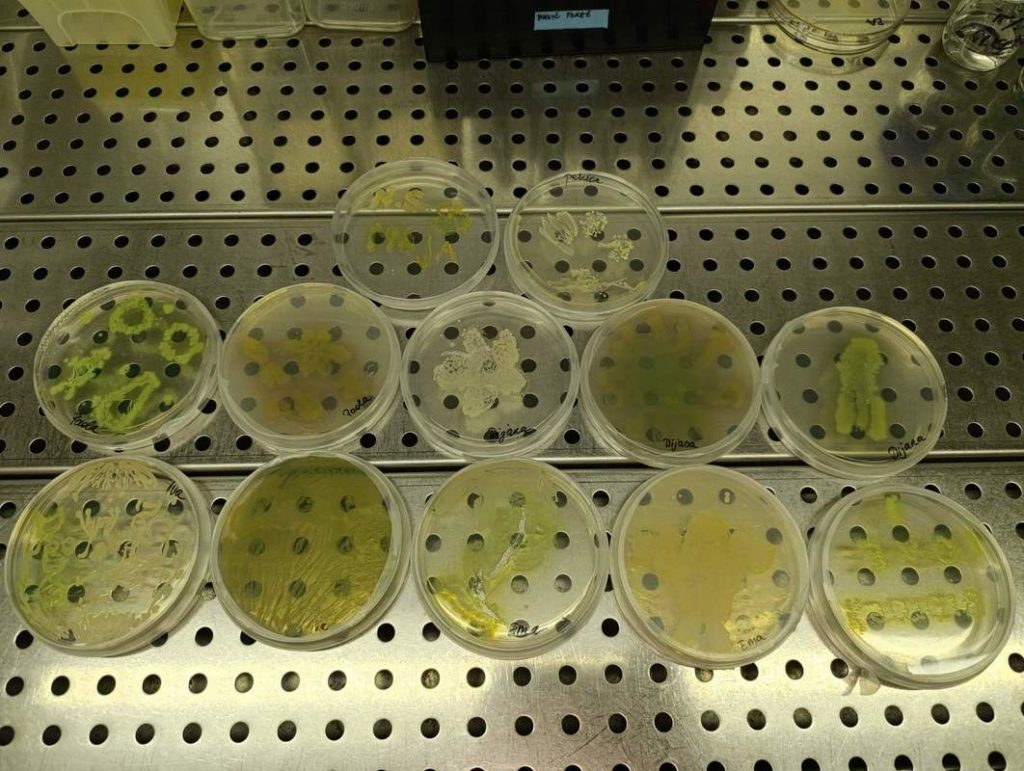

Na Odjelu za biologiju 13. svibnja 2025. godine održana je radionica pod nazivom „PetriArt – kada kultura postane umjetničko djelo“ za učenice Osnovne škole Kneževi Vinogradi. Učenice su se upoznale s osnovama rada u mikrobiološkom laboratoriju i uz to se kreativno izrazile crtanjem po agaru pomoću raznobojnih bakterijskih kultura. U osmišljavanju i realizaciji radionice sudjelovali su prof. dr. sc. Valentina Pavić, Lovro Mihajlović, univ. mag. biol. i Nikolina Sabo, univ. mag. educ. biol. et chem., djelatnici Odjela za biologiju, u suradnji s Majom Lesjak, univ. mag. educ. biol. et chem., nastavnicom biologije u Osnovnoj školi Kneževi vinogradi. Na Danu otvorenih vrata Osnovne škole Kneževi Vinogradi 21. svibnja 2025. godine učenice su predstavile rezultate svog rada, a Nikolina Sabo posjetiteljima je prezentirala Odjel za biologiju.